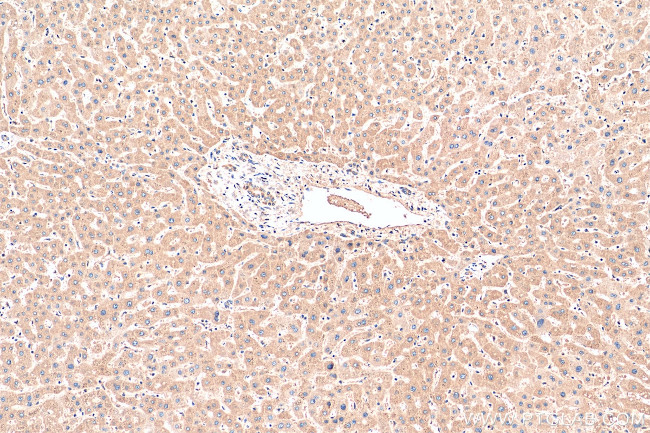
P3H2 Antibody in Immunohistochemistry (Paraffin) (IHC (P))
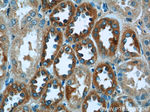
P3H2 Antibody in Immunohistochemistry (Paraffin) (IHC (P))
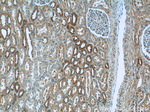
P3H2 Antibody in Immunohistochemistry (Paraffin) (IHC (P))
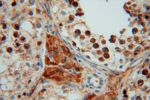
P3H2 Antibody in Immunohistochemistry (Paraffin) (IHC (P))
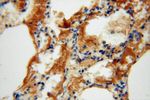
P3H2 Antibody in Immunohistochemistry (Paraffin) (IHC (P))

Search
Proteintech
P3H2 Polyclonal Antibody
{{$productOrderCtrl.translations['antibody.pdp.commerceCard.promotion.promotions']}}
{{$productOrderCtrl.translations['antibody.pdp.commerceCard.promotion.viewpromo']}}
{{$productOrderCtrl.translations['antibody.pdp.commerceCard.promotion.promocode']}}: {{promo.promoCode}} {{promo.promoTitle}} {{promo.promoDescription}}. {{$productOrderCtrl.translations['antibody.pdp.commerceCard.promotion.learnmore']}}
产品信息
15723-1-AP
种属反应
已发表种属
宿主/亚型
分类
类型
抗原
偶联物
形式
浓度
规格
纯化类型
保存液
内含物
保存条件
运输条件
产品详细信息
Immunogen sequence: ASIEAREDL TMFVKRHKLE SELIKSAAEG LGFSYTEPNY WIRYGGRQDE NRVPSGVNVE GAEVHGFSMG KKLSPKIDRD LREGGPLLYE NITFVYNSEQ LNGTQRVLLD NVLSEEQCRE LHSVASGIML VGDGYRGKTS PHTPNEKFEG ATVLKALKSG YEGRVPLKSA RLFYDISEKA RRIVESYFML NSTLYFSYTH MVCRTALSGQ QDRRNDLSHP IHADNCLLDP EANECWKEPP AYTFRDYSAL LYMNDDFEGG EFIFTEMDAK TVTASIKPKC GRMISFSSGG ENPHGVKAVT KGKRCAVALW FTLDPLYREL ERIQADEVIA ILDQEQQGKH ELNINPKDEL (179-527 aa encoded by BC005029)
靶标信息
This gene encodes a member of the prolyl 3-hydroxylase subfamily of 2-oxo-glutarate-dependent dioxygenases. These enzymes play a critical role in collagen chain assembly, stability and cross-linking by catalyzing post-translational 3-hydroxylation of proline residues. Mutations in this gene are associated with nonsyndromic severe myopia with cataract and vitreoretinal degeneration, and downregulation of this gene may play a role in breast cancer. Alternatively spliced transcript variants encoding multiple isoforms have been observed for this gene.
仅用于科研。不用于诊断过程。未经明确授权不得转售。
生物信息学
蛋白别名: leprecan-like 1; Leprecan-like protein 1; myxoid liposarcoma associated protein 4; Myxoid liposarcoma-associated protein 4; procollagen-proline 3-dioxygenase 2; Prolyl 3-hydroxylase 2; prolyl 3-hydroxylase 3; unnamed protein product
基因别名: 4832416N06; AW553532; LEPREL1; MCVD; MLAT4; P3H2
UniProt ID: (Human) Q8IVL5, (Mouse) Q8CG71
Entrez Gene ID: (Human) 55214, (Mouse) 210530